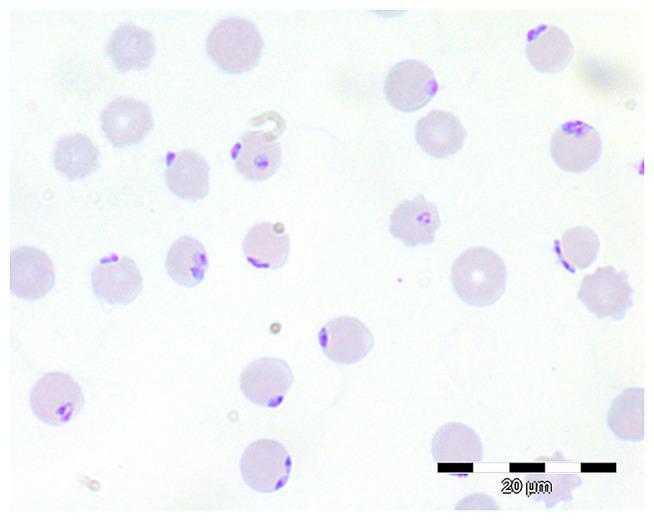
https://cdn.ncbi.nlm.nih.gov/pmc/blobs/52f1/7522169/1411b9ecb31c/fvets-07-00649-g0002.jpg

德国北部一个肉牛养殖场因[具体病因未给出]引发的牛巴贝斯虫病的出现与流行病学情况。
Emergence and Epidemiology of Bovine Babesiosis Due to on a Northern German Beef Production Farm.
作者信息
Springer Andrea, Höltershinken Martin, Lienhart Fabienne, Ermel Sandra, Rehage Jürgen, Hülskötter Kirsten, Lehmbecker Annika, Wohlsein Peter, Barutzki Dieter, Gietl Christine, Baumgärtner Wolfgang, Hoedemaker Martina, Strube Christina
机构信息
Institute for Parasitology, Centre for Infection Medicine, University of Veterinary Medicine Hannover, Hanover, Germany.
Clinic for Cattle, University of Veterinary Medicine Hannover, Hannover, Germany.
出版信息
Front Vet Sci. 2020 Sep 15;7:649. doi: 10.3389/fvets.2020.00649. eCollection 2020.
, transmitted by the tick , is the most common cause of bovine babesiosis in northern Europe and plays a role as a zoonotic pathogen. However, several studies have indicated a decline of prevalence in Europe during the last decades. Here, we investigate the epidemiology of bovine babesiosis on a beef production farm in northern Germany, which had not been affected by babesiosis until an initial outbreak in 2018. In June 2018, 21 adult cattle died, showing classical symptoms of babesiosis. merozoites were detected in blood smears of clinically affected animals and the species was confirmed by PCR and sequencing of a part of the 18S rRNA gene. In 2018, screening of the farm's entire stock by PCR revealed that -positive animals were present in only one of five herds grazing on different pastures. In the following year, further babesiosis cases occurred in multiple herds. In March 2020, 95 cattle were tested for anti- antibodies and 36 of them (37.89%) had positive titres. To investigate the local prevalence in ticks, 1,430 questing ticks (555 larvae, 648 nymphs, 227 adults) were collected on the farm's pastures and subjected to PCR for detection. DNA could not be detected, but showed an overall prevalence of 0.49% (7/1,430; 0.88% [2/227] of adult ticks, 0.77% [5/648] of nymphs, 0.00% [0/555] of larvae). was detected in 0.42% (6/1,430) of ticks (0.44% [1/227] of adult ticks, 0.77% [5/648] of nymphs, 0.00% [0/555] of larvae) and in 0.07% (1/1,430) of ticks (0.00% [0/227] of adult ticks, 0.15% [1/648] of nymphs, 0.00% [0/555] of larvae). Despite the fact that no -positive ticks were found, the collected data suggest a geographical spread of the pathogen on the farm. Bovine babesiosis remains a disease of veterinary importance in Europe and may cause considerable economic losses when (re-)emerging in non-endemic areas, especially as awareness for the disease among veterinarians and farmers declines.
由蜱传播,是北欧牛巴贝斯虫病最常见的病因,也是一种人畜共患病原体。然而,多项研究表明在过去几十年中其在欧洲的流行率有所下降。在此,我们调查了德国北部一个肉牛养殖场的牛巴贝斯虫病流行病学情况,该养殖场在2018年首次爆发疫情之前未受巴贝斯虫病影响。2018年6月,21头成年牛死亡,表现出巴贝斯虫病的典型症状。在临床患病动物的血涂片中检测到裂殖子,并通过PCR和对18S rRNA基因部分序列进行测序确认了该物种。2018年,通过PCR对该养殖场的全部存栏进行筛查,结果显示在不同牧场放牧的五个牛群中只有一个牛群存在阳性动物。在接下来的一年里,多个牛群又出现了巴贝斯虫病病例。2020年3月,对95头牛进行了抗巴贝斯虫抗体检测,其中36头(37.89%)抗体滴度呈阳性。为了调查蜱中该病原体的当地流行情况,在该养殖场的牧场收集了1430只正在寻找宿主的蜱(555只幼虫、648只若虫、227只成虫),并对其进行PCR检测以检测病原体。未检测到巴贝斯虫DNA,但巴贝斯虫总体流行率为0.49%(7/1430;成虫为0.88%[2/227],若虫为0.77%[5/648],幼虫为0.00%[0/555])。检测到双芽巴贝斯虫的蜱占0.42%(6/1430)(成虫为0.44%[1/227],若虫为0.77%[5/648],幼虫为0.00%[0/555]),卵形巴贝斯虫占0.07%(1/1430)(成虫为0.00%[0/227],若虫为0.15%[1/648],幼虫为0.00%[0/555])。尽管未发现阳性蜱,但收集到的数据表明该病原体在该养殖场存在地理扩散。牛巴贝斯虫病在欧洲仍然是一种具有兽医重要性的疾病,当在非流行地区(重新)出现时可能会造成相当大的经济损失,尤其是随着兽医和农民对该疾病的认识下降。